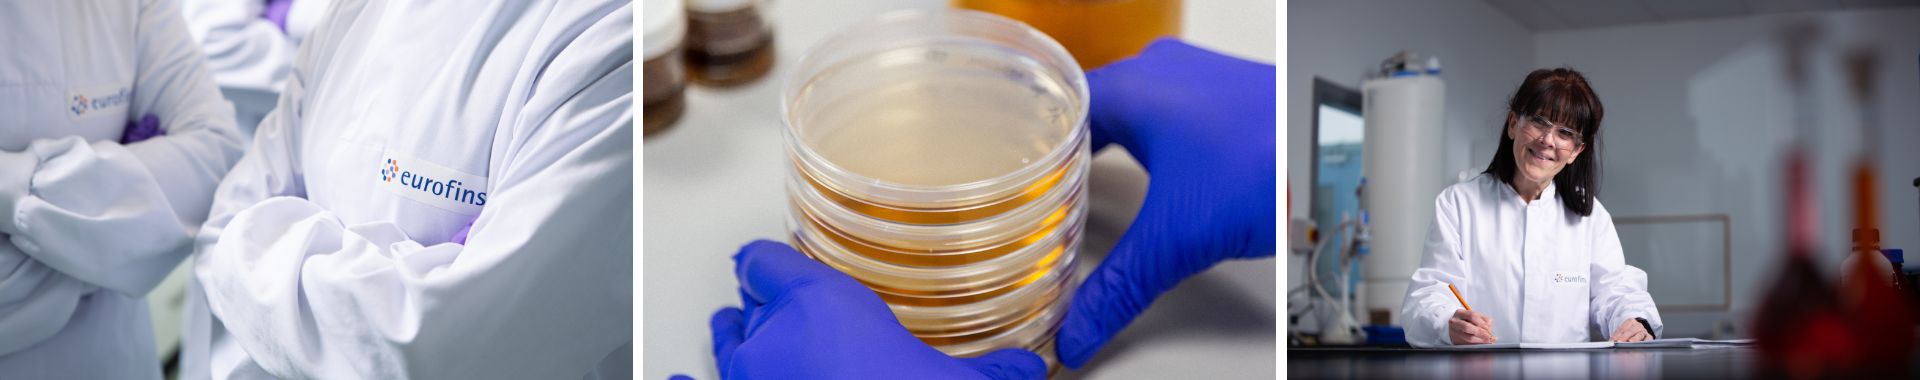
Disinfectant Testing (1)

Disinfectant Testing
Contact Us
In the Pharmaceutical, Industrial, Medical and Veterinary industries, the subject of disinfectant validation is attracting ever increasing attention from regulatory bodies such as MHRA, HPRA and FDA.
Companies are now expected to be able to demonstrate conclusively that their disinfectants of choice are effective under the conditions in which they are used.
The newly released Annex 1 now states that your disinfectants should be validated. It states that validation should occur to show the effectiveness of your disinfectants "in the specific manner in which they are used," meaning use conditions should be considered, and validation should consider mechanical actions, contact times, surface materials and hold times. It is therefore important to review and re-validate the efficacy of your disinfectants periodically to ensure they are effective against the current common microbial flora found in your facility.
There are several compelling reasons for outsourcing disinfectant validation:
1. Steep learning curve:
Disinfectant testing has a long, steep learning curve and can be extremely time consuming for those not fully familiar with the methods.
2. Occasional testing:
For most companies, the testing is either one off or occasional, meaning employees may be taken away from other work, or may require additional training.
3. Investigational nature of the work:
The occasional testing, combined with the investigative nature of the work means there is no understanding of what results may be expected.
4. Trending and advice:
Eurofins MGS laboratories perform disinfectant testing on a daily basis, for many customers, and as a result we have a database of results which we use to check for out of trend results and offer advice should disinfectant performance be disappointing.
The CEN approach has 3 phases, and there are many different tests which can be performed to confirm the efficacy of disinfectants. Eurofins MGS Laboratories have been performing disinfectant testing since 1998, and are experts in the following methods, as well as many other disinfectant test methods:
| Phase | Step | Description | Industrial | Medical | Veterinary |
| Phase 1 | Basic bactericidal and fungicidal activity. | BS EN 1040* BS EN 1275* BS EN 14347 |
|||
| Phase 2 | Step 1 | Quantitative suspension testing to evaluate bactericidal, fungicidal and sporicidal activity. | BS EN 1276* BS EN 1650* BS EN 13704* |
BS EN13727* BS EN 13624* BS EN 14348 |
BS EN 1656* BS EN 1657* BS EN 14204 |
| Phase 2 | Step 2 | Surface testing | BS EN 13697* | BS EN 14561* BS EN 14562* BS EN 14563 BS EN 1499* BS EN 1500* BS EN 12791 BS EN 16615* |
BS EN 14349 |
| Phase 3 | Field Trials - yet to be developed | ||||
* UKAS Accredited Standard
The BS EN methods themselves are of value as a means of determining the efficacy of a disinfectant under controlled conditions. However, in normal working conditions, environmental organisms are encountered which can provide a greater challenge to disinfectant products.
The nature of the BS EN methods is such that they can be adapted to form the basis of more informative studies into the performance of disinfectants in practice. This can yield valuable information about the comparative performances of a number of products and the adapted methods facilitate studies of the effects of changes in product concentration, contact time, test temperature and the use of water produced in your facility, all of which help to evaluate your specific in house cleaning procedures.
It is the wider application of the standard BS EN methods that is the key to a thorough, coherent disinfectant validation program.
Eurofins MGS are also able to perform other disinfectant tests, including the validation of handwashes and handrubs, and testing against specific pathogens:
BS EN 1499 and BS EN 1500 are specifically designed to test handwashes and handrubs. Both methods involve the use of a panel of volunteers who use the product under test and a reference material.
BS EN 12791 evaluates the sustained action of surgical hand disinfectants.
BS EN 14348 is a quantitative suspension test for the evaluation of mycobactericidal activity of chemical disinfectants for instruments used in the medical area.
BS EN 14204 is a quantitative suspension test for the evaluation of mycobactericidal activity of chemical disinfectants for instruments used in the veterinary area.
BS EN 13623 Chemical disinfectants and antiseptics — Quantitative suspension test for the evaluation of bactericidal activity against Legionella of chemical disinfectants for aqueous systems.
For companies not wishing to follow the CEN approach, a number of alternative methods are available for the evaluation of disinfectant products, including but not limited to AOAC, ASTM, EPA/OECD methods.
Annex 1 now states that when working in a sterile environment, disinfectants should also be sterile.